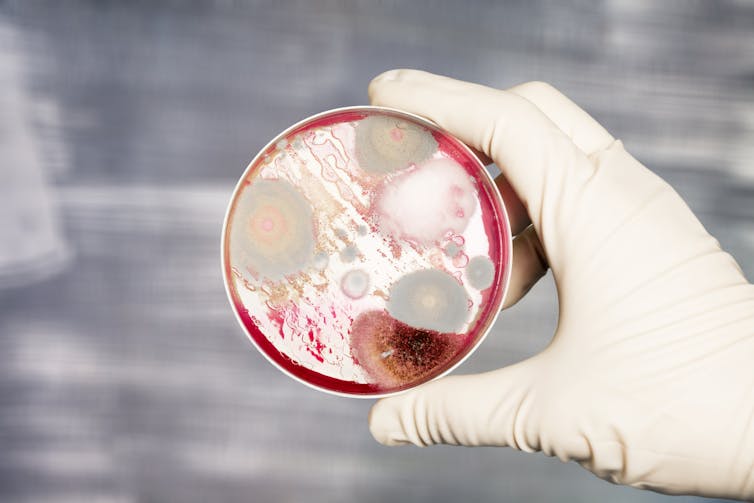

the bacteria that live in and on us
- Written by Mark Blaskovich, Senior Research Officer, The University of Queensland
Bacteria are everywhere, including in and on our bodies. There are estimated to be as many bacteria in a human body as there are human cells.
Much like Pig Pen in the comic strip Peanuts, we actually carry around a cloud of bacteria in the air surrounding us.
Bacteria are found in soil, in food, and on surfaces we touch all the time – our mobile phones, for example, are teeming with them.
Bacteria can be good. Our gut is full of bacteria, which help digest food. Fermented foods such as sauerkraut and yoghurt are made with, and contain, millions of bacteria.
But bacteria can be bad, too. They may infiltrate our skin and other defences and get into the wrong places, causing infection. There are several possible reasons for this, and they depend on the nature of the bacteria themselves, the types of entry points bacteria have available to them, and other factors.
What is the human microbiome?How do our bodies fight bacteria?
Our bodies are normally very good at keeping bacteria where they generally don’t cause damage – on skin surfaces and in the digestive tract – and away from areas that should be “sterile” – such as the urinary tract or blood. Mostly this is done by using barriers that physically prevent the entry of bacteria.
But every so often bacteria make it through. The body then relies on a variety of internal defences to identify, isolate and deactivate the invading bacteria. Bacterial infections occur when one of these mechanisms is breached.
Physical damage to the skin, such as cuts and scrapes, or surgery, can allow bacteria ready access to the inside of the body, potentially introducing more bacteria than the body’s defence systems can handle.
Alternatively, when the internal defence systems are damaged, such as for patients with weaker immune systems (those undergoing chemotherapy, or those with immune system disorders), bacteria can become established in places they are not meant to be.
Both cases are more likely when the bacteria are particularly opportunistic at invading and growing. These types of bacteria are called pathogenic. This is why we have infections caused by certain types of bacteria, such as Staphylococcus aureus or Escherichia coli, and not others, such as Lactobacillus bulgaricus and Streptococcus thermophilus (the bacteria in yoghurt).
The ability of bacteria and humans to peacefully live with each other explains why “superbugs” – bacteria that have become resistant to being killed by antibiotics – can be present, but not immediately dangerous.
Antibiotic-resistant bacteria on our skin
The prototypical drug-resistant bacteria – methicillin-resistant S. aureus (MRSA, or golden staph) – has been around for decades. Almost everyone has S. aureus on their skin, usually around the nose, but (depending on the country and study), anywhere from 1 in 50 to around 1 in 5 people carry a version of S. aureus that has acquired resistance to some types of antibiotics.
As long as it stays on the skin, resistant S. aureus doesn’t cause a problem, and people generally don’t know they carry it. But if it manages to breach the body’s barriers and cause an infection, it can lead to harm if the right type of antibiotic is not used to treat it. It’s usually at this point, during attempts to treat an infection, that it becomes identified as a resistant bacteria.
Read more: We know _why_ bacteria become resistant to antibiotics, but _how_ does this actually happen?
In a similar manner, a recent report found that another common skin bacteria found on everyone, Staphylococcus epidermidis, also has high levels of resistance. The researchers looked at patients with S. epidermidis infections predominantly acquired in a hospital setting. What is not known is how widespread the resistant bacteria are, as there has never been systematic testing for resistance in healthy individuals.
As with S. aureus, the resistant S. epidermidis only becomes a real threat when it has started an infection in the body that needs to be treated with antibiotics.
A more general threat posed by both of these resistant strains is that, as they are on the surface of the skin, they can be readily transferred between people, so the overall presence of resistant bacteria can increase.

There is significant fear about another class of bacteria that have acquired resistance to almost all antibiotics, resulting in high levels of death in infected patients. These are Gram-negative bacteria, a type of bacteria that already has an additional protective outer layer that makes it more difficult to kill with antibiotics – even before becoming resistant.
The highly resistant species of concern include E. coli, Klebsiella pneumoniae, Pseudomonas aeruginosa, Acinetebacter baumannii, and Neisseria gonorrhoeae. For example, death rates for patients with invasive infections caused by one specific type of resistant Gram-negative bacteria, carbapenem-resistant Enterobacteriaceae (CRE), are estimated to be over 40%. The CRE bacteria are resistant to one of the newer and more powerful classes of antibiotics we have – carbapenems – and are usually also resistant to most other antibiotics.
Read more: Five of the scariest antibiotic-resistant bacteria in the past five years
More than 20 patients died from CRE in Florida during 2008-12, while 6 out of 17 patients infected with a K. pneumoniae superbug died in a US hospital outbreak in 2011. Fortunately these cases are still very rare in Australia – for now.
But with increasing levels of international travel, when people visit countries with much higher levels of resistance in the general population and environment – places such as Greece, India, Brazil, Thailand, and China – they can be exposed to, and become silent carriers of, the deadly bacteria. It is important that, if in hospital for an infection or surgery after an overseas trip, you let your doctor know that you have been travelling.
Finally, good hand washing is one of the most effective ways to help prevent the spread of these silent assassins.
Authors: Mark Blaskovich, Senior Research Officer, The University of Queensland